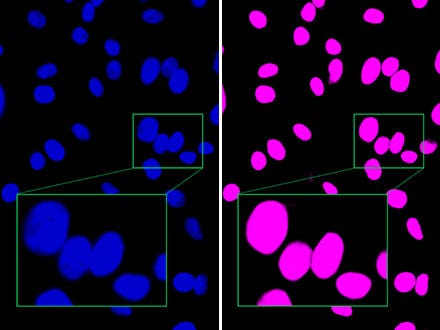
Abbildung 2: Im Vergleich zum Fluoreszenzbild (links) unterscheidet TruAI von Olympus nahe beieinander liegende Zellkerne deutlich voneinander (rechts) und erlaubt eine Erkennung mit hoher Genauigkeit.

Anwendungshinweisen
Genaue und effiziente Mikroskopie-Bildanalyse mit TruAI und Deep Learning
Einführung
Untersuchungen erfordern häufig Daten von Mikroskopbildern. Zur genauen Bildanalyse ist eine Segmentierung wichtig, um den Zielbereich der Analyse aus dem Bild zu extrahieren. Eine gängige Segmentierungsmethode ist die Anwendung von Schwellenwerten für die Intensität oder die Farbe des Bildes.
Dies kann jedoch zeitaufwändig sein und den Probenzustand beeinträchtigen. Bildanalyseverfahren der nächsten Generation wie unsere Bildverarbeitungssoftware cellSens mit TruAI und Deep-Learning reduzieren die Risiken einer Probenschädigung und erreichen gleichzeitig eine hohe Effizienz und Genauigkeit.
Anwendungsbeispiele mit TruAI
1) Markerfreie Kerndetektion und Segmentierung
Um die Anzahl der Zellen zu zählen, Kerne in Zellen und Geweben zu lokalisieren und die Zellfläche zu bewerten, nutzen Forscher üblicherweise die Fluoreszenzfärbung von Kernen, um diese anhand der Fluoreszenzintensität zu segmentieren.
Im Gegensatz dazu kann TruAI die Zellkernsegmentierung mit Hellfeldbildern durchführen. Dazu wird mit den Ergebnissen der Kernsegmentierung aus Hellfeld- und Fluoreszenzbildern ein neuronales Netz trainiert.
Dieses selbstlernende Mikroskopiekonzept macht eine Fluoreszenzfärbung des Zellkerns überflüssig, sobald das neuronale Netzwerk erstellt ist. Weitere Vorteile:
- Minimierung des Zeitaufwands für die Zellkernfärbung
- Keine Beeinträchtigung der Zellen durch Anfärben
- Keine Fototoxizität, kein Ausbleichen
- Erfassung zusätzlicher Probeninformationen durch Ergänzung eines weiteren Kanals

Abbildung 1
Abbildung 2
Abbildung 1: Während das Hellfeldbild (links) aufgrund der ungefärbten Zellen einen minimalen Kontrast aufweist, erkennt TruAI die Zellkerne mit hoher Genauigkeit (rechts).
Abbildung 2: Im Vergleich zum Fluoreszenzbild (links) unterscheidet TruAI von Olympus nahe beieinander liegende Zellkerne deutlich voneinander (rechts) und erlaubt eine Erkennung mit hoher Genauigkeit.
Whitepaper lesen
2) Quantitative Analyse von fluoreszenzmarkierten Zellen bei ultraschwachem Licht
Fluoreszierende Marker sind wertvolle Tools für moderne mikroskopische Zellstudien. Das dazu erforderliche intensive Anregungslicht kann jedoch zu Lichtschäden oder Fototoxizität führen und die Lebensfähigkeit der Zellen nachweislich beeinträchtigen. Auch wenn keine direkte Wirkung zu beobachten ist, kann starke Lichteinwirkung das natürliche Verhalten der Zellen beeinflussen und zu unerwünschten Effekten führen.
Bei Langzeitexperimenten mit lebenden Zellen ist eine minimale Lichtexposition während der Fluoreszenzmikroskopie ideal. Aus technischer Sicht erfordert die Belichtung mit extrem wenig Licht die Analyse von Bildern mit sehr niedrigem Signalpegel und folglich geringem Signal-Rausch-Abstand. Mit TruAI von Olympus lassen sich Bilder mit schwachen Signalen robust und präzise analysieren.



Abbildung 3: Das Ergebnis der Erkennung von Zellkernen (rechts) in einem Fluoreszenzbild (links) mit ausreichender Leuchtdichte mit einer herkömmlichen Methode (Auswertung einer Leuchtdichteschwelle).
Abbildung 4: Das Ergebnis der Erkennung von Zellkernen (rechts) mit der gleichen konventionellen Methode wie in Abbildung 3 in Fluoreszenzbildern (links) mit extrem niedrigem Signal-Rausch-Abstand aufgrund des schwachen Anregungslichts. Die geringe Erkennungsgenauigkeit ist offensichtlich.
Abbildung 5: Das Ergebnis der Erkennung von Zellkernen (rechts) mit TruAI in einem Fluoreszenzbild (links) mit extrem niedrigem Signal-Rausch-Abstand aufgrund des schwachen Anregungslichts. Es ist gut erkennbar, dass die Genauigkeit genauso hoch ist wie in Abbildung 3 und deutlich höher als in Abbildung 4.
White Paper lesen
3) Segmentierung nach morphologischen Merkmalen
Mit dem herkömmlichen Ansatz (Schwellenwerte für Intensität und Farbe) ist es sehr schwierig, eine hochpräzise Segmentierung eines Bilds auf der Grundlage morphologischer Merkmale zu erreichen. Daher mussten Zählung und Messung jedes Mal manuell durchgeführt werden.
Im Gegensatz dazu ermöglicht TruAI eine hocheffiziente und genaue Segmentierung nach morphologischen Merkmalen. Sobald das neuronale Netz die Segmentierungsergebnisse aus manuell markierten Bildern gelernt hat, kann es die gleiche Methodik auf weitere Datensätze anwenden. Zum Beispiel können neuronale Netze, die mit manuell markierten Bildern trainiert wurden, mitotische Zellen zählen (siehe nachstehendes Bildmaterial).

Abbildung 6

Abbildung 7
Abbildung 6: Vorhersage mitotischer Zellen mit TruAI (grün).
Abbildung 7: Es werden zwar viele Zellen angezeigt, aber nur die sich teilenden Zellen werden erkannt (rechts).
4) Segmentierung von Gewebeproben
TruAI kann auch zur Segmentierung von Gewebeproben verwendet werden. Zum Beispiel können Nierenglomeruli, die mit herkömmlichen Methoden schwer zu unterscheiden sind, mit TruAI segmentiert werden.

Abbildung 8

Abbildung 9
Abbildung 8: Vorhersage von Glomeruli-Positionen auf einem Maus-Nierenschnitt mit TruAI (blau).
Abbildung 9: TruAI erfasst und detektiert die Glomeruli-Merkmale (rechts).
Zusammenfassung
Herkömmliche Segmentierungsmethoden können problematisch sein und die Proben schädigen. Unsere cellSens-Bildgebungssoftware mit Deep Learning ermöglicht eine genaue und effiziente Segmentierung unter zellschonenden Bedingungen, beispielweise durch markerfreie Bildgebung oder ultraschwache Beleuchtung. Die Software erleichtert auch die Segmentierung von Gewebeproben anhand ihrer morphologischen Merkmale.
Verwendete Produkte

FV5000
Konfokales Laser-Scanning-Mikroskop
- Außergewöhnliche Klarheit, Geschwindigkeit und Zuverlässigkeit dank bahnbrechender Innovationen
- SilVIR™-Detektoren liefern Quantifizierung auf Photonenebene, außergewöhnliche Empfindlichkeit und ein extrem hohes Signal-Rausch-Verhältnis.
- Unübertroffener Dynamikbereich erfasst das gesamte Signalspektrum und verhindert Sättigung.
- Hochgeschwindigkeits-2K-Resonanzabtastung und hochdichte 8K-Galvo-Abtastung auf einer Plattform
- Die FLUOVIEW Smart™ Software vereinfacht die Bedienung durch intuitive Steuerelemente und KI-gestützte Automatisierung.
- TruResolution™-Autokorrekturring optimiert den Fokus für über 20 Objektive
- Das modulare Design unterstützt bis zu 10 Laserlinien und zukünftige Multiphotonen-Upgrades.
- Laser Power Monitor (LPM) gewährleistet eine stabile Ausleuchtung und reproduzierbare Ergebnisse über die Zeit.

FV5000MPE
Multiphotonen-Laser-Scanning-Mikroskop
- Kompakte, fasergekoppelte Laser ermöglichen tiefe, quantitative Bildgebung in streuendem Gewebe.
- Gleichzeitige MPE-Laseranregung mit einer, zwei oder drei Linien für die Bildgebung in mehreren Millimetern Tiefe.
- Die Technologien SilVIR™, TruAI und TruSight™ sorgen für ein herausragendes Signal-Rausch-Verhältnis und maximale Klarheit bei der Bildgebung.
- MPE-optimierte Objektive, TruResolution™-Korrekturring und automatische IR-Laserausrichtung sorgen für einen scharfen Fokus.
- Als Upgrade für das FV5000-System oder als komplettes MPE-System
- Für fortgeschrittene Multiphotonenanwendungen sind vollständig abstimmbare Laserkonfigurationen verfügbar.

Konfokales Laser-Scanning-Mikroskop
FV4000
- Überragender dynamischer Bereich für die Bildgebung vom Makrobereich bis hin zu subzellulären Strukturen
- Multiplexing von bis zu sechs Kanälen gleichzeitig mit der TruSpectral Technologie
- Neu gestalteter Hochgeschwindigkeitsscanner mit hoher Auflösung für die Bildgebung von fixierten Zellen und Lebendzellen
- Verbesserte Tiefenauflösung und Lichtempfindlichkeit mit bahnbrechenden NIR-Funktionen und bewährter Optik
- Zuverlässiger SilVIR Detektor mit hoher Wiederholgenauigkeit
- Branchenführende * zehn Laserlinien mit größerem Spektralbereich von 405 nm bis 785 nm
*Stand Oktober 2023.

Mikroskopsysteme für Lebendzellen
IXplore Live
- Physiologisch aussagekräftige Daten bei minimaler Störung der Zellen durch Olympus Echtzeit-Controller
- Verschiedene Optionen zur Steuerung der Versuchsbedingungen bei der Bilderfassung zur Erhaltung der Zellviabilität
- Genaue und zuverlässige Scharfeinstellung bei Experimenten mit Zeitrafferaufnahmen durch das Olympus Hardware-Autofokus-System (mit Z-Drift-Ausgleich)
- Erfassung der tatsächlichen Form der Zellen mit der Olympus Silikonöl-Immersionsoptik

Automatisiertes Fluoreszenzmikroskop
BX63
- Das vollständig motorgesteuerte System ermöglicht die Automatisierung komplexer mehrdimensionaler Experimente
- Präziser motorischer Z-Trieb
- Höchste Stabilität dank fest angebrachtem Tisch

Lösungen für Life Science
cellSens
Das Layout der Benutzeroberfläche der cellSens Software mit intuitiver Bedienung und nahtlosem Arbeitsablauf kann benutzerindividuell verändert werden. Die cellSens Software ist in verschiedenen Versionen verfügbar und bietet eine Vielzahl an Funktionen, die für spezifische Bildgebungsanforderungen optimiert sind. Funktionen wie der Graphic Experiment Manager und der Well Navigator können die 5D-Bildaufnahme erleichtern. TruSight Dekonvolution verbessert die Auflösung, und mit dem Conference Mode können Aufnahmen geteilt werden.
- Mehr Effizienz bei der Versuchsdurchführung mit der TruAI Deep Learning Segmentierungsanalyse für eine markerfreie Zellkernerkennung und Zellzählung
- Modulare Imaging-Software-Plattform
- Intuitive, anwendungsorientierte Benutzeroberfläche
- Großer Funktionsumfang von der einfachen Momentaufnahme bis hin zu komplexen, mehrdimensionalen Echtzeitexperimenten